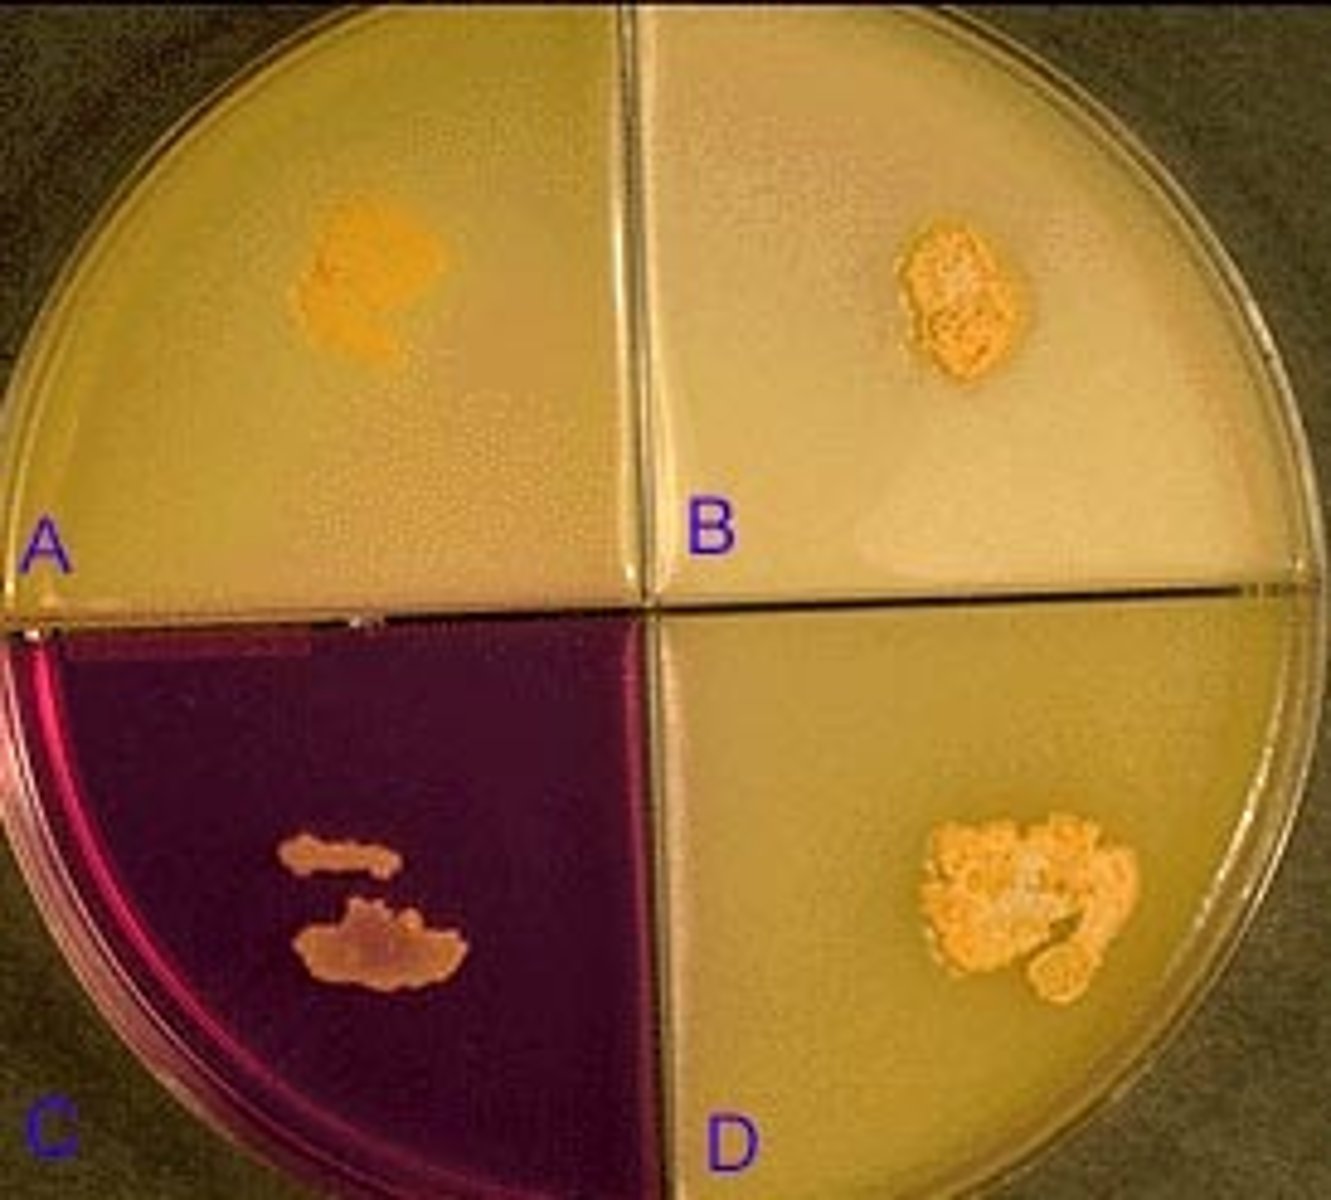
<p>Illustrated in this photograph is an agar quadrant plate containing casein (A), tyrosine (B), nitrate (C) and xanthine (D). None of the substrates have been hydrolyzed and nitrate has been reduced. The most likely identification is:</p><p>A. Nocardia asteroides</p><p>B. Nocardia brasiliensis</p><p>C. Streptomyces griseus</p><p>D. Actinomadura madurae</p>
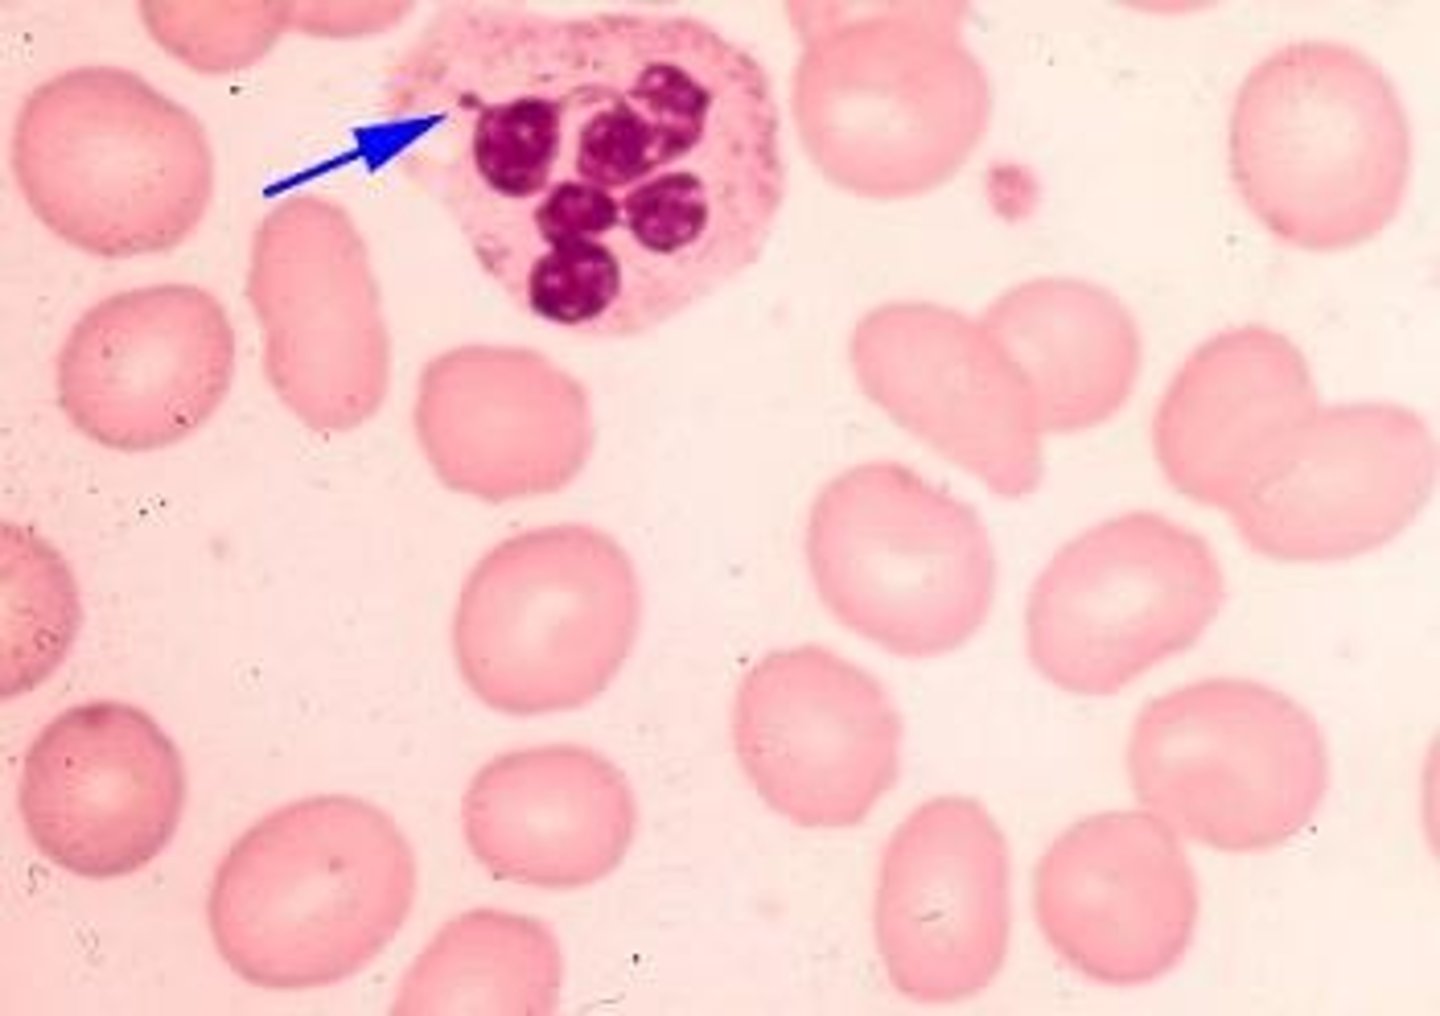
<p>True/False</p><p>The nuclear appendage at the tip of the arrow is a normal finding in females but not in males.</p>
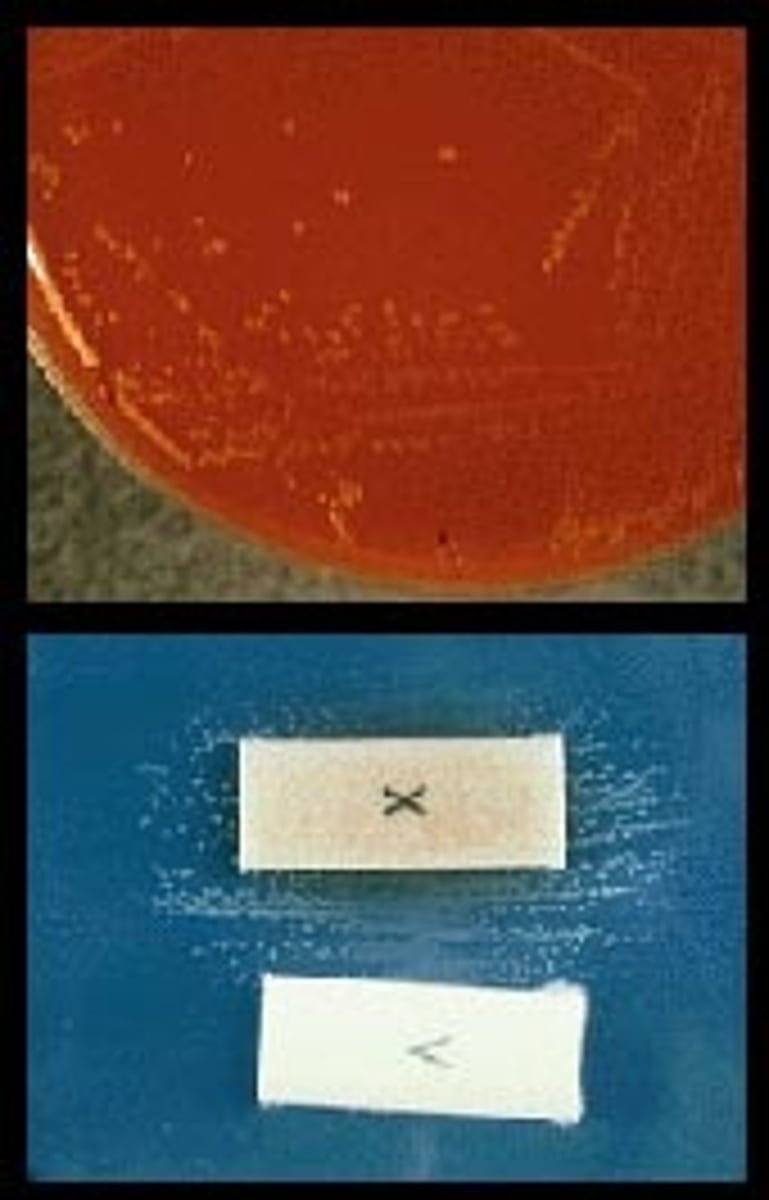
<p>Acute obstructive epiglottitis, both in adults and children, is caused by the bacterial species shown in this split screen photograph. The colonies recovered on chocolate agar (upper frame) required both hematin and NAD, (as shown by colony growth only between the X and V strips in the lower frame). The most likely identification is:</p><p>A. Haemophilus parainfluenzae</p><p>B. Haemophilus influenzae</p><p>C. Haemophilus aphrophilus</p><p>D. Haemophilus haemolyticus</p>
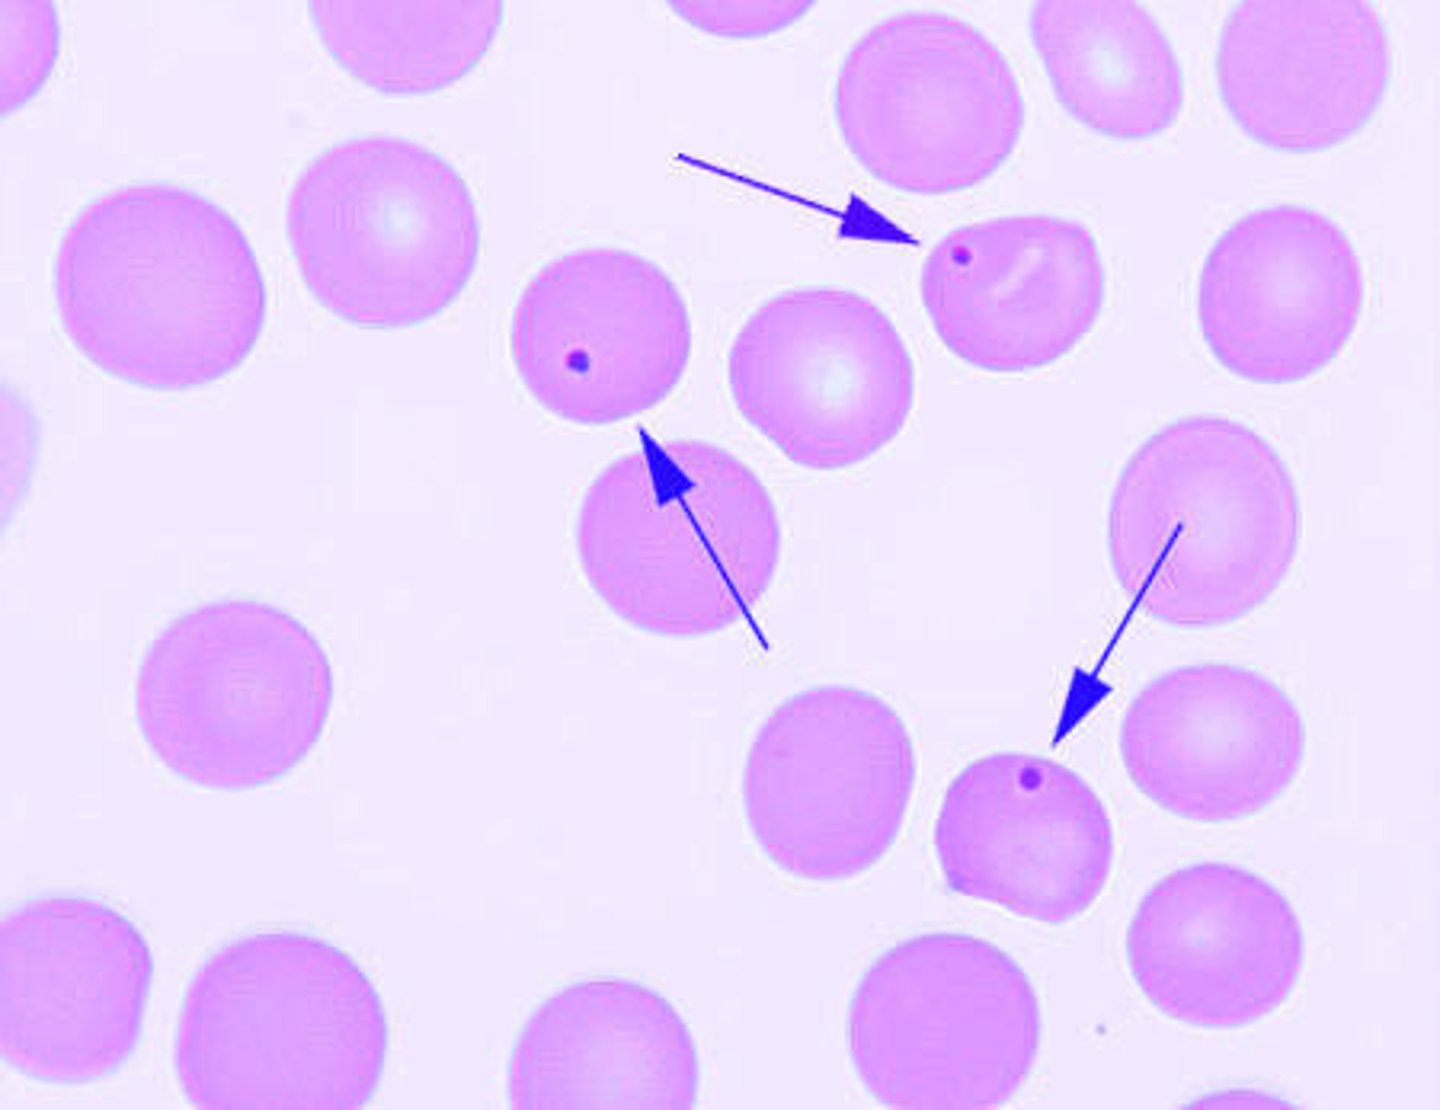
<p>Single erythrocyte inclusions which are large, round, smooth and purplish-blue staining are most likely:</p><p>A. Howell-Jolly bodies</p><p>B. Heinz bodies</p><p>C. Basophilic stippling</p><p>D. Cabot rings</p>

MLT ASCP Practice Test Questions board practice
1/99
There's no tags or description
Looks like no tags are added yet.
Name | Mastery | Learn | Test | Matching | Spaced |
|---|
No study sessions yet.
100 Terms
B;
The correct answer for this question is 1300 mg/dL. The laboratorian performed a 1:4 dilution by adding 0.25 mL (or 250 microliters) of patient sample to 750 microliters of diluent. This creates a total volume of 1000 microliters. So, the patient sample is 250 microliters of the 1000 microliter mixed sample, or a ratio of 1:4. Therefore, the result given by the chemistry analyzer must be multiplied by a dilution factor of 4. 325 mg/dL x 4 = 1300 mg/dL.
After experiencing extreme fatigue and polyuria, a patient's basic metabolic panel is analyzed in the laboratory. The result of the glucose is too high for the instrument to read. The laboratorian performs a dilution using 0.25 mL of patient sample to 750 microliters of diluent. The result now reads 325 mg/dL. How should the techologist report this patient's glucose result?
A. 325 mg/dL
B. 1300 mg/dL
C. 975 mg/dL
D. 1625 mg/dL
A;
Conversion of only the slant to a pink color in a Christensen's urea agar slant is produced by bacterial species that have weak urease activity. The reaction in the slant to the right is often produced by Klebsiella species, as an example. Strong urease activity is indicated by conversion of the slant and the butt of the tube to a pink color, as seen in the tube to the left. The slant only reaction in the right tube may be seen early on if only the slant had been inoculated; however, with a strong urease producer, both the slant and the butt would turn. Therefore, the reaction is dependent on the strength of urease activity. If the media had outdated for a prolonged period, either there would be no reaction or the appearance of only a faint pink tinge, either in the slant, the butt or both, again depending on the strength of urease production by the unknown organism.
The urease reaction seen in the Christensen's urea agar slant on the far right indicates:
A. Weak activity
B. Strong activity
C. Slant only inoculated
D. Use of outdated medium

D;
The steps in the PCR process are:
1. Denaturation (Turning double stranded DNA into single strands.)
2. Annealing/Hybrization (Attachment of primers to the single DNA strands.)
3. Extension (Creating the complementary strand to produce new double stranded DNA.)
What is the first step of the PCR reaction?
A. Hybridization
B. Extension
C. Annealing
D. Denaturation
B;
Isotonic or normal saline is a 0.85 % solution of sodium chloride in water.
The concentration of sodium chloride in an isotonic solution is :
A. 8.5 %
B. 0.85 %
C. 0.08 %
D. 1 molar
C;
In DIC, or disseminated intravascular coagulation, the prothrombin time is increased due to the consumption of the coagulation factors due to the tiny clots forming throughout the vasculature. This is also the reason that the fibrinogen levels and platelet levels are decreased. Finally FDP, or fibrin degredation products, are increased due to the formation and subsequent dissolving of many tiny clots in the vasculature. The FDPs are the pieces of fibrin that are left after the fibrinolytic processes take place.
Which of the following laboratory results would be seen in a patient with acute Disseminated Intravascular Coagulation (DIC)?
A. prolonged PT, elevated platelet count, decreased FDP
B. normal PT, decreased fibrinogen, decreased platelet count, decreased FDP
C. prolonged PT, decreased fibrinogen, decreased platelet count, increased FDP
D. normal PT, decreased platelet count, decreased FDP
B;
A dilution commonly used for a routine sperm count is a 1:20.
A dilution commonly used for a routine sperm count is:
A. 1:2
B. 1:20
C. 1:200
D. 1:400
B;
Prozone effect (due to antibody excess) will result in an initial false negative in spite of the large amount of antibody in the serum, followed by a positive result as the specimen is diluted.
The prozone effect ( when performing a screening titer) is most likely to result in:
A. False positive
B. False negative
C. No reaction at all
D. Mixed field reaction
A;
One of the key characteristics to the identification of Nocardia asteroides is its inability to hydrolyze casein, tyrosine or xanthine, as shown in this photograph. Nitrates are reduced to nitrites. Both Nocardia brasiliensis and Actinomadura madurae hydrolyze both casein and tyrosine; Streptomyces griseus hydrolyzes all three of the substrates.
Illustrated in this photograph is an agar quadrant plate containing casein (A), tyrosine (B), nitrate (C) and xanthine (D). None of the substrates have been hydrolyzed and nitrate has been reduced. The most likely identification is:
A. Nocardia asteroides
B. Nocardia brasiliensis
C. Streptomyces griseus
D. Actinomadura madurae
A;
Since hemoglobin is measured spectrophotometrically on hematology analzyers, interference from lipemia or icteric specimens can lead to decreased light detected and measured through the sample and therefore inaccurate hemoglobin results occur.
On an electronic cell counter, hemoglobin determination may be falsely elevated caused by the presence of:
A. Lipemic or icteric plasma
B. Leukocytopenia or Leukocytosis
C. Rouleaux or agglutinated RBCs
D. Anemia or Polycythemia
False
A patient who has a primarily vegetarian diet will most likely have an alkaline urine pH. A low-carbohydrate diet as well as the ingestion of citrus fruits can also lead to a more alkaline urine sample.
A patient who has a primarily vegetarian diet will most likely have an acid urine pH.
A;
During primary hypothyroidism, where a defect in the thryoid gland is producing low levels of T3 and T4, the TSH level is increased. TSH is released in elevated quantities in an attempt to stimulate the thryoid to produce more T3 and T4 as part of a feedback mechanism.
Serum TSH levels five-times the upper limit of normal in the presence of a low T4 and low T3 uptake could mean which of the following:
A. The thyroid has been established as the cause of hypothyroidism
B. The thyroid is ruled-out as the cause of hypothyroidism
C. The pituitary has been established as the cause of hypothyroidism
D. The diagnosis is consistent with secondary hyperthyroidism
A;
Fusarium species is the most likely associated with mycotic keratitis.
Trichophyton rubrum is a dermatophyte that commonly causes an itching, scaling skin infection of the feet, known as tinea pedis. Scedosporium apiospermum is commonly associated with sinusitis. Aspergillus niger typically causes otitis externa and can also be associated with sinusitis.
Which of the following species or organisms is the most likely to be the cause of mycotic keratitis (fungal eye infection)?
A. Fusarium species
B. Trichophyton rubrum.
C. Scedosporium apiospermum
D. Aspergillus niger
A;
Oxalate, EDTA, and citrate are anticoagulants that inhibit clot formation.
Which of the following blood additives is most useful for serum collection:
A. Polymer barrier
B. Oxalate
C. EDTA
D. Citrate
B;
This patient is most likely suffering from an immediate-acting coagulation inhibitor; most commonly, lupus anticoagulant. Notice that the addition of normal pooled plasma does not correct upon initial or incubated mix, which means that the inhibitor is not time or temperature-dependent.
Factor VIII is not the correct answer as a factor deficiency would have corrected upon the addition of normal pooled plasma. Factor VII is not the correct answer, as the aPTT assay does not account for factor VII activity or concentration.
The laboratorian completed the mixing study ordered for John Doe. The results are as follows:
Initial aPTT result: 167 seconds
Initial 1:1 Mix with Normal Pooled Plasma: 158 seconds
Incubated 1:1 Mix with Normal Pooled Plasma: 150 seconds
Which of the choices below would most likely explain the results for this patient?
A. Factor VIII deficiency
B. Immediate-acting coagulation inhibitor
C. Time/temperature-dependent coagulation inhibitor
D. Factor VII deficiency
A;
HbsAg is positive in acute and chronic Hepatitis B infections, since the antigen is found on the actual surface of the virus. HbeAg is present in the blood when the hepatitis B viruses are replicating, indicating an active infection. Anti-Hbc IgM is present due to the immune response to the presence of the hepatitis core antigen and indicates an acute infection. Anti-HBs is generally interpreted as indicating recovery and immunity from hepatitis B virus infection, according to the CDC.
Given the following results, what is the immune status of the patient?
HbsAg: positive
HbeAg: positive
Anti-HBc IgM: positive
Anti-HBs: negative
A. acute infection
B. chronic infection
C. immunization
D. susceptible
A;
Albumin is a "negative" acute phase protein since it is found in decreased levels during acute phase response. Alpha-1-antitrypsin, fibrinogen, and ceruloplasmin are all "positive" acute phase proteins that are found in increased levels during acute phase response.
Which one of the following usually shows a decrease during an acute phase response?
A. Albumin
B. Alpha-1 Antitrypsin
C. Fibrinogen
D. Ceruloplasmin
False
Because lower titers could be due to both passive and immune anti-D, in the absence of results that suggest immune anti-D, routine antibody titration is not a good use of time compared to assuming that anti-D is passive.
Best practice guidelines do NOT recommend routine titration for women known to be injected with RhIg and exhibiting a 2+ or less reaction with D+ red cells consistent with passive anti-D from RhIg.
True/False
A pregnant female who received RhIg at 28 weeks gestation has a positive antibody screen at delivery. If the antibody has been confirmed as anti-D alone and reacts 1+ in the indirect antiglobulin test with D+ red cells, performing a titration to investigate if the anti-D is immune is good practice.
1. B
2. D
3. A
4. C
Red to Brown Urine: porphobilinogen, hematuria, myoglobinuria, etc.
Green: Food colorings; Increased carotene in the diet;
Pseudomonas aeruginosa infection
Yellow: bilirubin, bile pigments
White: phosphates, other crytals
Match urine color with substance that might have been responsible:
1. Phosphates
2. Bilirubin
3. Pseudomonas
4. Porphobilinogen
A. Blue to green
B. White
C. Red to brown
D. Yellow
A;
The production of long, tapered phialides is one of the key identifying features of Trichoderma species. In contrast, Penicillium species, produce phialides with blunt ends.
The phialides of Beauveria species are geniculate, forming a zig-zag pattern.
The arrows in the image on the right point to single, long, tapered phialides that extend laterally from either side of the hyphae. This is an identifying feature of which of the fungi listed below?
A. Trichoderma species
B. Penicillium species
C. Beauveria species

A;
The DAT is most likely to be negative in ABO HDFN. It's possible that the washing done as part of the DAT may break the bonds between anti-A (or anti-B) and the newborn's poorly developed A (or B) antigens.
For which of the following antibodies is the DAT most likely to be negative when testing a newborn for possible HDFN?
A. anti-A
B. anti-c
C. anti-D
D. anti-K
E. anti-Fya
B;
This scenario's answer can be calculated by first deciding what the total quality control labor costs are as well as what the total consumable costs are. In this case, if quality control is run 3 times per day, a total of 1095 quality control runs are performed each year. The direct labor cost of $2.63 multiplied by 1095 quality control runs equals $2879.85 per year in quality control direct labor. The hospital pays $354.00 per month on quality control consumables, which equals $4248.00 per year. The total quality control costs in a year are equal to $2879.85 + $4248.00 = $7127.85. If 76,000 new chemistry tests panels are peformed each year, the total quality control cost per new chemistry test panel will be $0.09.
General Hospital is considering the addition of a new chemistry panel containing 12 tests. The laboratory is asked to calculate the total cost of quality control per new chemistry test panel. Quality control must be performed 3 times per day (every 8 hours). The labor cost per quality control test for this panel is $2.63. A month's worth of quality control reagent costs $354.00. What is the total quality control cost per new chemistry test panel if 76,000 of these new panels are performed each year?
A. $0.01
B. $0.09
C. $0.04
D. $1.70
B;
A normal hemoglobin molecule consists of a tetramer, of four heme and four globin chains, with a molecular weight of 64,500 daltons. Each of the four units can bind a molecule of oxygen for transport to the body's tissues. In the image shown below, there are four monomers (2 red globin chains and 2 blue globin chains) which form the entire hemoglobin tetramer structure. The green portions represent the 4 heme groups.
A normal hemoglobin molecule is comprised of the following:
A. Ferrous iron and four globin chains
B. Four heme and four globin chains
C. Four heme and one globin chains
D. One heme and four globin chains

D;
IgE levels are often increased in patients with allergic disease. IgE binds to the membranes of mast cells and basophils, and if specific antigen is present to react with the IgE molecule, degranulation of these cells occurs, releasing histamines, and other substances into the blood or tissues.
Which of the following immunoglobulin classes is chiefly responsible for the degranulation of mast cells and basophils:
A. IgG
B. IgA
C. IgM
D. IgE
A;
Ammonium biurate crystalsare typically round, irregularly spiked and yellow-brown in color.
A microscopic examination of a normal urine pH 8.0 shows 2+ yellow-brown thorny spheres which are MOST probably:
A. ammonium biurate crystals
B. ampicillin crystals
C. amorphous urate crystals
D. crenated red cells
E. waxy casts
B;
Hemoglobin electrophoresis uses an electric field to separate hemoglobin molecules based on differences in net electrical charge. The rate of electrophoretic migration is also dependent on the ionic radius of the molecule, the viscosity of the solution through which it is migrating, the electrical field strength, temperature, and the type of supporting medium used.
Electrophoretic separation of hemoglobin fundamentally relies on:
A. Size differences of molecules
B. Net charge differences of molecules
C. Concentration differences of molecules
D. Shape variations of molecules
True
Regardless of rounding up or down, when calculating RhIg dosage, such facilities always add one vial. For example:
1.4 = 1 +1 = 2 vials
1.5 = 2 +1 = 3 vials
True/False
For those facilities that in the interest of safety use a special calculation for RhIg dosage, regardless if they round up or round down, they always add one vial.
B;
Using the formula on the right,
Cells/µL = 370 x 100 / 18 x 0.1
Cells/µL = 37000 / 1.8
Cells/µL = 20556 or 2.06 x 104
A sample of cerebrospinal fluid is diluted 1:100; the standard 9 squares of a hemocytometer are counted on each side for a total of 18 large squares.
Side 1-- 186 nucleated cells counted
Side 2-- 184 nucleated cells counted
total nucleated cells = 370
Using the standard hemocytometer formula shown on the right, what is the nucleated cell count per microliter (µL)?
A. 1.03 x 10^4
B. 2.06 x 10^4
C. 4.62 x 10^4
D. 9.25 x 10^4

D;
Shigella and Salmonella are not found as normal flora in the gastrointestinal tract.
Which of the following are not considered normal flora of the gastrointestinal tract:
A. Lactobacillus
B. Clostridium
C. Peptostreptococcus
D. Shigella
True
The small drumstick-like nuclear extension (Barr body) marked by the blue arrow is a chromatin mass which may represent a chromosomal remnant.
These nuclear appendages are found in normal XX females, but would not be present in normal XY males. If such an appendage is found in a phenotypic male, Klinefelter's syndrome (XXY male) may be identified clinically. The appendage has a "drumstick" morphology.
True/False
The nuclear appendage at the tip of the arrow is a normal finding in females but not in males.
A;
In DNA complementary base pairing, guanine and cytosine pair and adenine and thymine base pair. Remembering the phrase "G-CAT" helps one recollect correct pairing.
Which nitrogen base would bind with a guanine nucleotide in forming double-stranded DNA?
A. Cytosine
B. Uracil
C. Thymine
D. Adenine
B;
To make a 1 : 10 dilution, 270 µL of diluent should be added to 30 µL of sample, .
A spinal fluid that is slightly hazy is briefly examined microscopically. The technologist performing the count decides to make a 1:10 dilution using 30 µL of sample. What volume of diluent should be used?
A. 70 µL
B. 270 µL
C. 300 µL
D;
Intravascular hemolysis is typically associated with increased levels of serum (plasma) LDH and bilirubin, and an increased number of reticulocytes. Serum LDH is found in higher levels during intravascular hemolysis due to fact that high levels of LDH are normally found within the red cells, but is now being spilled into the bloodstream via red cell lysis. Bilirubin is a breakdown product of hemoglobin, which has also been spilled into the bloodstream from broken red blood cells via hemolysis. Reticulocytosis is a reflection of the release of an increased number of immature red blood cells from the marrow to account for the red blood cells that are lost through hemolysis. This is a normal response. Failure to show an increased reticulocyte count with hemolytic episodes or hemorrhage would indicate an ineffective erythropoiesis (possible bone marrow function problem).
Which of these blood levels will increase during intravascular hemolysis?
A. Serum (plasma) LDH
B. Serum (plasma) bilirubin
C. Reticulocytes
D. All of the above
E. None of the above
True
According to the paper by Jedrzejas, S. pneumoniae indeed is the cause of most fatal cases of community-acquired pneumonia.
True/False
Streptococcus pneumoniae is the most common cause of fatal community-acquired pneumonia.
C;
A slow, progressive drift of values away from the mean is called a trend. Trends occur when a particular analyte value slowly and progressively changes in one direction from one run to the next. Monitoring data for trends is part of good laboratory practice and is one indicator of many that helps laboratorians determine whether the measurement system is fucntioning appropriately.
A slow, progressive drift of values away from the mean is called a:
A. Coefficient of Deviation
B. Dispersion
C. Trend
D. Variance
E. Shift
C;
Protein in urine can be confirmed using sulfosalicylic acid (SSA) precipitation. The SSA reagent is added to a small volume of urine. Acidification causes precipitation of protein in the sample, which is subjectively graded as trace, 1+, 2+, 3+ or 4+. SSA reaction will detect albumin, globulins, and Bence-Jones proteins.
Which of the following would be the most appropriate method to confirm a positive protein from a urine dipstick:
A. Immunoelectropheresis
B. Heat precipitation
C. Sulfosalicylic acid precipitation
D. Protein electrophoresis
C;
Patients who develop severe sepsis or septic shock commonly have increased plasma lactic acid values.
Patients who develop severe sepsis or septic shock commonly have __________ plasma lactic acid values.
A. Decreased
B. Normal
C. Increased
B;
DAT ( Direct Antiglobulin Test ).
When AHG or Coombs serum is used to demonstrate that red cells are antibody coated in vivo, the procedure is termed:
A. Indirect technique
B. Direct technique
C. Hemagglutination technique
D. Hemolysis technique
D;
RAST tests, or Radioallergosorbent tests, are used to screen for an allergy to a specific substance or substances if a person presents with allergy-like symptoms.
The assay which is most helpful in identifying specific allergens is:
A. Complement fixation
B. C-reactive proteins
C. RIA
D. RAST
B;
Though it may not be required, TDM should still be used to confirm adequate dosing. Genotyping does not make TDM redundant.
A PM will metabolize the drug more slowly and therefore will need lower doses. CYP2D6 metabolizes many different drugs; it is not associated with just one class of drugs. Anytime a drug is taken that competes for the same metabolizing enzyme as another drug, there is potential for the concentrations of both drugs to be increased.
A patient has been characterized as a CYP2D6 poor metabolizer (PM) after genotyping. Which of the following statements is not true?
A. The patient will likely need lower doses of CYP2D6-metabolized drugs.
B. The patient is less likely to require therapeutic drug monitoring (TDM) since the genotype is known.
C. CYP2D6 metabolizes many drugs, and so attention must be given to the doses of drugs from different classes.
C;
One method of calculating a glomerular filtration rate is using creatinine and urine volume to determine creatinine clearance. The equation is as follows:
Creatinine Clearance = (urine creatinine X urine flow rate) / plasma creatinine; where urine flow rate = volume in mL /24 hours x h/60 min)
In this case = creatinine clearance = 124 X (2200/24 x hour/60) / 2 = 94.7 or 95 ml/min
What is the glomerular filtration rate for a patient with a serum creatinine of 2 mg/dL, if the urine creatinine was 124 mg/dL and the urine volume was 2.2 L/24 hrs?
A. 9.5 mL/min
B. 13.6 mL/min
C. 95 mL/min
D. 136 mL/min
E. 1.36 mL/min
B;
Listeria are non-capsulated, non-acid-fast, ß-hemolytic, gram-positive bacilli that have a characteristic tumbling motility. They are found primarily in the environment and in the human GI tract. Since L. monocytogenes multiplies intracellularly, control of listeriosis requires cell-mediated immunity; thus, immunocompromised patients (such as newborns) are at high risk.
Which bacterial species is a common agent of neonatal bacteremia?
A. Streptococcus pyogenes
B. Listeria monocytogenes
C. Staphylococcus aureus
D. Enterococcus faecium
D;
Platelets do not circulate in inactivated, spiny forms. The spiny, sticky form of the platelet is initiated once the platelets become activated in response to blood vessel damage.
Which of the following is not true in terms of platelet characteristics?
A. Produced in the bone marrow by megakaryocytes.
B. Possess an inherent sticky property that aids in adhesion and aggregation.
C. Have a lifespan of roughly 9-12 days.
D. Are normally found circulating in their inactive, spiny form.
B;
HLA-DR is a MHC class II(major histocompatibility complex) surface receptor on the cellular surface which is encoded by the human leukocyte antigen complex, or HLA.
DR antigens are found in which of the following systems:
A. Kell system
B. HLA system
C. Duffy system
D. ABO system
B;
Serological diagnosis of active or recent infection generally requires the demonstration of IgM antibody, or the demonstration of a fourfold rise in the titer of specific IgG antibody.
Which of the following would be considered most significant as it relates to serological testing:
A. Presence of an antibody titer is generally diagnostic
B. Rise of antibody titers is diagnostic
C. Concentration of antibody is diagnostic
D. Cross reactivity is not significant
D;
Although cysteine-blood agar was traditionally used, F. tularensis will also grow on commercially available Thayer-Martin and chocolate agar which have been enriched with supplemental nutrients.
Which of the following media would you use to isolate Francisella tularensis:
A. Sheep-blood agar
B. Lowenstein-Jensen media
C. Bordet-Gengou media
D. Cysteine-blood agar
A, C, & D
The structures involved in the production of semen include the prostate, the seminal vesicles, and the bulbourethral gland, along with the testes and epididymis.
Semen is produced as a combination of secretions from the different regions of the male reproductive tract. Each fraction differs in chemical composition and function.
Spermatozoa are produced in the testes. They mature in the epididymis. The testes also produce testosterone and inhibin.
Fluid from the seminal vesicles accounts for approximately 70% of semen volume. The seminal vesicles are the source of fructose in semen. Fructose is used by the spermatozoa as an energy source.
The prostate gland supplies about 20% of the volume of semen. Its fluids include acid phosphatase and proteolytic enzymes that lead to coagulation and subsequent liquefaction of semen. The prostate also contains most of the IgA found in semen.
The bulbourethral gland produces mucoproteins that make up about 5% of the volume of semen.
The pituitary gland is not directly involved in the production of semen; instead hormones are released which stimulate the production of sperm. The urethra is not involved in the production of semen.
Which of the following are directly involved in the production of semen?
A. Prostate
B. Pituitary gland
C. Seminal vesicles
D. Bulbourethral gland
E. Urethra
A;
Joint pain is a common early symptom of HH. Cirrhosis of the liver, cardiomyopathy, and diabetes are late symptoms of HH.
What is a common early symptom of hereditary hemochromatosis (HH)?
A. Joint pain
B. Cirrhosis of the liver
C. Diabetes
D. Cardiomyopathy
D;
When an antigen comes in contact with the skin, the antigen is processed by cells in the epidermis and come in contact with T lymphocytes. T lymphocytes recognize the antigen as foreign and circulate through the bloodstream back to the epidermis and produce an inflammatory response to eliminate the antigen, but this immune response can produce a characteristic rash in the skin called contact dermititis.
Contact dermatitis is mediated by:
A. B lymphocytes
B. Macrophages
C. Polymorphonuclear cells
D. T lymphocytes
E. Chemokines
B;
The mandatory waiting period between blood donations is 56 days, or eight weeks.
The accepted interval between blood donations is:
A. 12 weeks
B. 8 weeks
C. 6 weeks
D. Depends on hematocrit level
C;
Free T4 is affected the least by changes in plasma proteins during pregnancy.
Which of the following thyroid function assays is affected least by pregnancy:
A. Total T3
B. Total T4
C. Free T4
C;
The organisms in this image are demonstrating a gram-variable phenomenon. For the most part, the organisms are staining primarily gram-negative, however, on the tips of some of the rods, there is a gram-positive staining morphology. This can be defined as gram-variable.
Which of the following best describes the organisms seen in this illustration:
A. gram-positive
B. gram-negative
C. gram-variable
D. acid-fast

D;
This antibody is found in the serum of Le(a-b-) secretors.
Which one of these Lewis blood group system phenotypes usually produces anti-Lea?
A. Le(a+b+)
B. Le(a+b-)
C. Le(a--b+)
D. Le(a--b-)
B;
Calculation:
Cells Counted (in this case the average of both sides) X dilution factor (in this case 100) / # of squares counted (in this case 9) X area of each square (1mm2) X 0.1mm (depth factor)
So, in this problem:
158 x 100 / 9 x 1 x 0.1mm = 17555.55/mm3 (can be converted to 17.5 x 109/L*)
*There are 1,000,000 mm3 in a liter (L). So 17555.55 X 1,000,000 = 17.5 x 109/L
A manual white blood cell count was performed by the hematology technologist. The cell counts for both sides were 152 and 164 respectively. All nine large squares were counted on each side. The dilution for this kit was pre-measured at 1:100. What should the technologist report as the white cell count?
A. 177.5 x 10^9/L
B. 17.5 x 10^9/L
C. 1.75 x 10^9/L
D. 175 x 10^9/L
C;
hs-CRP is a recent marker of chronic inflammation. New measurements of CRP in lower levels (hs-CRP) are now measured to monitor risk of cardiovascular disease.
Select the statement that best describes hs-CRP?
A. hs-CRP is a measurement of acute inflammation and is used to monitor these conditions
B. hs-CRP is an anti-inflammatory adipokine synthesized by adipocytes
C. hs-CRP is a marker of chronic inflammation and measured to predict the risk of cardiovascular disease
D. hs-CRP is decreased in inflammatory conditions and measured to predict a return of inflammation
B;
The body of a tapeworm is composed of successive segments known as proglottids. Each mature proglottid has both male and female reproductive structures.
What is the anatomical feature of a tapeworm that possesses both male and female reproductive structures?
A. Brood capsule
B. Proglottid
C. Rostellum
D. Scolex
D;
The A and B antigens are present on the red cells of an AB patient. H antigen is a precursor to the ABO antigens.
An individual with type AB blood will demonstrate the complete absence of which of the following antigen sites?
A. A
B. B
C. H
D. None of the above
B;
Abrupt change in temperature is one of the risk factors in which a sickling event may occur.
Dehydration, hypoxia, and physical exertion, rather than excessive intake of fluids, inhaling oxygen, and sedentary lifestyle, are all additional risk factors in which sickling events may occur.
Which of these could cause a sickling event?
A. Excessive intake of water
B. Fluctuations in temperature
C. Oxygen inhalation
D. Sedentary life-style
1. D
2. C
3. A
4. B
Match each of the following definitions associated with heart disease and heart failure to the term that it defines.
1. Congestive heart failure
2. Infarction
3. Ischemia
4. Angina
A. An inadequate blood supply that decreases availability of oxygen.
B. Chest pain caused by inadequate supply of oxygen to heart myocardium.
C. An area of tissue death that occurs due to lack of oxygen.
D. A left ventricular dysfunction resulting from aging, hypertension, atherosclerosis or muscle damage from an AMI or repeated AMIs.
C;
Hemoglobin F has a high affinity for oxygen. When Hb F is elevated, cells containing Hb S are more oxygenated and do not sickle as readily as they would if Hb F were not present or present in small quantities.
Which hemoglobin, when elevated, acts as a protection against sickling in patients with HbS?
A. Hemoglobin A2
B. Hemoglobin C
C. Hemoglobin F
D. Hemoglobin G
D;
After collection all blood should be stored at 1 - 6oC, unless it is going to be used as a source of platelets.
A refrigerator used to store whole blood must be able to maintain a temperature in the ranges of:
A. 0 - 4 degrees Celsius
B. 2 - 4 degrees Celsius
C. 2 - 8 degrees Celsius
D. 1 - 6 degrees Celsius
B;
Haemophilus influenzae is both X and V factor dependent for growth, and is the most common cause of obstructive laryngitis and epiglottitis. H. parainfluenzae is only V-factor dependent and causes only mild pharyngitis, rarely obstructive in nature. H. aphrophilus can be part of the normal upper respiratory flora in humans, does not cause pharyngitis, and is not X or V-factor dependent for growth. Although H. haemolyticus is both X and V-factor dependent, it is beta hemolytic on blood agar and is generally considered non pathogenic.
Acute obstructive epiglottitis, both in adults and children, is caused by the bacterial species shown in this split screen photograph. The colonies recovered on chocolate agar (upper frame) required both hematin and NAD, (as shown by colony growth only between the X and V strips in the lower frame). The most likely identification is:
A. Haemophilus parainfluenzae
B. Haemophilus influenzae
C. Haemophilus aphrophilus
D. Haemophilus haemolyticus
1. A
2. A
3. B
4. A
5. B
6. B
A cardiovascular risk marker is an analyte in a body fluid that can be measured by the clinical laboratory and has been associated with the development of cardiovascular disease. Examples of risk markers include: LDL-C, triglycerides, and hs-CRP.
A cardiovascular risk factor is a condition (not a laboratory analyte) that is associated with an increased risk of developing cardiovascular disease. Examples of risk factors include: smoking, obesity, diabetes and hypertension.
Determine if each of the following is a cardiovascular risk marker or a cardiovascular risk factor.
1. Smoking
2. Obesity
3. Low density lipoprotein (LDL)
4. Hypertension
5. Triglycerides
6. High sensitivity-C-reactive protein (hsCRP)
A. Cardiovascular risk factor
B. Cardiovascular risk marker
A;
The cell depicted with the arrow in this image is an atypical (reactive) lymphocyte. These cells are common found in certain viral infections, especially infectious mononucleosis. Notice the larger size and abundant cytoplasm present in this lymphocyte. There is also apparent vacuoliation which is a key feature of atypical lymphocytes. The chromatin pattern of this cell as well as the overall shape, color and size rules out the monocyte, macrophage, and mesothelial cell choices.
A patient with an infectious mononucleosis infection presents in the emergency room. Physicians order a spinal tap which is immediately sent to the laboratory for review. Please identify the cell in the image below from this patient's cerebrospinal fluid sample.
A. Reactive Lymphocyte
B. Monocyte
C. Macrophage
D. Mesothelial Cell

C;
Enterobius vermicularis infection occurs through swallowing ova. Pinworm infections including those caused by Enterobius vermicularis, usually occur due to a fecal-oral route of transmission. According to the CDC, "Eggs are deposited on perianal folds. Self-infection occurs by transferring infective eggs to the mouth with hands that have scratched the perianal area. Person-to-person transmission can also occur through handling of contaminated clothes or bed linens. Enterobiasis may also be acquired through surfaces in the environment that are contaminated with pinworm eggs (e.g. , curtains, carpeting). Some small number of eggs may become airborne and inhaled. These would be swallowed and follow the same development as ingested eggs. Following ingestion of infective eggs, the larvae hatch in the small intestine and the adults establish themselves in the colon. The time interval from ingestion of infective eggs to oviposition by the adult females is about one month. The life span of the adults is about two months. Gravid females migrate nocturnally outside the anus and oviposit while crawling on the skin of the perianal area. The larvae contained inside the eggs develop (the eggs become infective) in 4 to 6 hours under optimal conditions . Retroinfection, or the migration of newly hatched larvae from the anal skin back into the rectum, may occur but the frequency with which this happens is unknown."
Enterobius vermicularis infection occurs through:
A. penetration of larvae through skin
B. penetration of adult through skin an resulting production of larvae
C. ingesting or inhaling ova
D. ingesting a segment of the adult worm
B;
Phase of reactivity is primarily at immediate spin (4+) and reactions get weaker at AHG (w+). There is no specific pattern of reactivity and the auto control is negative which rules out an autoantibody. This is a strong cold antibody which is still slightly present after incubation and washing.
Activation and binding of the antibody takes place at room temperature or colder. Eliminating this phase will prevent the antibody from binding. Cold antibodies usually are more of a nuisance to blood bankers and are not clinically significant.
When performing an antibody screen, both the screen cells are 4+ at immediate spin and W+ at AHG. The antibody panel shows 4+ reactions at immediate spin and W+ reactions at AHG and there is no specific match to the reaction pattern. The auto control is negative. What would be a logical next step?
A. Have patient redrawn
B. Repeat testing using warmed patient sample and reagents and just do AHG reading
C. Run an enzyme panel
A;
Since cimetidine inhibits CYP2D6, less amphetamine will probably need to be given since it will not be able to be metabolized as readily.
Most drug interactions are like this: one drug inhibits or competes with the same CYP450 as another drug. The end result is that higher concentrations of one, or both, drugs are present, leading to potential toxicity.
A patient is taking cimetidine for a stomach ulcer. This drug inhibits CYP2D6. The patient is now prescribed amphetamine for narcolepsy. Amphetamine is metabolized by CYP2D6. What would you predict?
A. The dose for the amphetamine needs to be lower than normal.
B. The dose for amphetamine needs to be higher than normal.
C. Nothing can be assumed until you know the patient's status (PM, EM, UM).
D. The two drugs can never be given together since they interact.
True
According to the paper abstracted from Curcurull and Espinosa, septic arthritis in patients under the age of 30 is most commonly associated with acute gonorrhea. It is also of interest that these authors also found that disseminated disease is the most common complication of acute gonorrhea, occurring in 0.5% - 3% of all cases.
True/False
Acute gonorrhea is the most common cause of septic arthritis in patients under 30 years of age.
A;
The end of the initial phase of HH treatment is considered when the serum ferritin decreases to between 20 and 50 ng/mL.
What is a typical finding for determining the endpoint for the initial or iron-depletion phase of treatment for hereditary hemochromatosis (HH)?
A. The serum ferritin decreases to between 20 and 50 ng/mL
B. The hepatic iron index returns to normal
C. The transferrin saturation drops below 20%
D. The serum iron falls to below 35 g/dL.
A;
Cholesterol levels do not fluctuate as triglycerides, fatty acids, lipoproteins, and chylomicrons do after an individual eats a meal. This is the reason that patients are told to fast; the laboratory needs a fasting sample to determine a lipid profile or panel which includes the latter four components.
Which of the following lipid tests is LEAST affected by the fasting status of the patient?
A. Cholesterol
B. Triglycerides
C. Fatty acids
D. Lipoproteins
E. Chylomicrons
False
Initially researchers thought that RhIg prevented anti-D production by clearing the infant's D-positive rbc sensitized with maternal anti-D, but we now know this is not true.
Currently, the mechanism by which RhIg prevents immunization to the D antigen is poorly defined. However, research shows that it likely involves down-regulation of antigen-specific B cells, ie., the B cells do not differentiate into antibody-excreting plasma cells as they normally would when presented with foreign antigens.
True/False
RhIg prevents anti-D production mainly by clearing antibody-sensitized D-positive rbc from maternal circulation.
D;
FAB M5 is acute monoblastic leukemia
FAB M1 is acute myeloblastic leukemia without maturation
FAB M3 is acute promyelocytic leukemia
FAB M4 is acute myelomonocytic leukemia
Which FAB designation is called the "true" monocytic leukemia and is characterized by monoblasts, promonocytes, and monocytes?
A. FAB Ml
B. FAB M3
C. FAB M4
D. FAB M5
B;
The clue to the identification of the colony seen in the upper frame is the gram stain in the lower frame, in which are seen short, rounded, gram positive bacilli, many of which possess distinct spores. As the colonies grew aerobically, the presence of spores indicates Bacillus species. The colonies are spreading, smooth, yellow-white and non-hemolytic. The lack of hemolysis and the small size of the bacterial cells suggests a species other than Bacillus cereus, the species causing most human infections. The isolate was identified as Bacillus circulans, which is consistent with the gram stain morphology. Clostridium septicum also produces spores; however, this species is an anaerobe and would grow poorly if at all and not produce spores aerobically. Listeria monocytogenes and Lactobacillus species are gram positive bacilli; however, neither of these produce spores.
The colonies seen in the upper frame, grown after 48 hours incubation aerobically at 35°C, and the accompanying gram stain in the lower frame are uncommonly associated with human disease, but have been associated with septicemia, bronchopneumonia, osteomyelitis and other infections, particularly in intravenous drug users. The most likely identification is:
A. Clostridium septicum
B. Bacillus circulans
C. Listeria monocytogenes
D. Lactobacillus species

A, B, & D
Certain recipients have increased risk for developing TA-GVHD. They are:
Neonates less than 4 months of age
Fetuses
Recipients with a congenital or acquired immunodeficiency, such as bone marrow or stem cell recipients, and patients receiving chemotherapy
recipients of donor units from a blood relative
Which of the following patients are at risk for transfusion-associated graft versus host disease (TA-GVHD) and require irradiated cellular blood products? (Choose all that apply)
A. Neonates less than 4 months of age
B. Recipients of donor units known to be from a blood relative.
C. Patients with chronic anemias.
D. Patient receiving chemotherapy who are immunocompromised.
E. Patients with a history of allergic reactions.
D;
Either immunofixation or immunoelectrophoresis can be used to confirm Bence-Jones proteinuria.
Which of the following methods would be used to confirm the presence of Bence-Jones protein in the urine:
A. Urine protein electrophoresis
B. Sulfosalicylic acid
C. Isoelectric focusing
D. Immunofixation
A;
Molarity x Molecular Weight x Volume = Grams
Molecular Weight (aka Formula Weight) =
2(1) + 32 + 4(16) = 98
So, 4 x 98 x 0.2L = 78.4g
What weight of H2SO4 is contained in 200 ml of a 4 molar H2SO4 solution? (Atomic weight: H= 1; S = 32; 0 = 16)
A. 78.4 gm
B. 156.8 gm
C. 39.2 gm
D. 15.68 gm
E. 84 gm
C;
Incompatiblity involving the ABO blood group system can cause the most severe type of transfusion reaction.
The cause of the most severe life-threatening hemolytic transfusion reactions is:
A. Anti-D
B. Anti-M
C. Anti-A, Anti-B, Anti-A, B
D. Anti-Fya
C;
The image shown in this question is depicting a rosette formation. Here the red blood cells are surrounding and adhering to the outside of the white blood cell.
What is the best description of the phenomenon seen in this illustration?
A. Rouleau formation
B. Cold agglutination
C. Rosette formation
D. Monocyte activation

B;
Any oxidase-positive organism can be excluded from the Enterobacteriaceae. The other characteristics are as a rule present in these organisms.
Which of the following is not true about members of the Enterobacteriaceae:
A. Gram-negative
B. Oxidase positive
C. Reduce nitrate to nitrite
D. Ferment glucose
1. B
2. A
3. C
Match the type of media with the phrase that best describes that media:
1. Differential
2. Selective
3. Enrichment
A. Media that contains agents that inhibit all but one specific organism.
B. Contains certain factors that allow colonies of specific organisms to appear different than other colonies.
C. Encourages the growth of specific types of organisms.
D;
Flow cytometry employs a combination of fluorescent antibody tagging of cells and analysis with laser light scatter.
What principle(s) of flow cytometry are employed when performing immunophenotyping:
A. Defraction gradients
B. Impedance
C. Defraction gradients and impedance
D. Fluorescent antibody tagging and light scatter
A;
The electrolyte panel consists of potassium, sodium, chloride, carbon dioxide. These analytes are also typically ordered within other panels as well, including the basic metabolic and complete metabolic panels.
An electrolyte panel (lytes, chem-4) consists of:
A. Potassium, Sodium, Chloride, Carbon dioxide
B. Potassium, Sodium, Chloride, Glucose
C. Potassium, Sodium, Chloride, Creatinine
D. Potassium, Sodium, Chloride, BUN
B;
If your reactions are strong at immediate spin (3+) and then get weaker at AHG (w+), it could mean the presence of a strong cold antibody.
Cold antibodies tend to be IgM and their optimum phase for reactivity is immediate spin. Incubation and washing of the sample may cause the agglutination that occurred at room temperature to break down. This would appear as a weaker reaction at AHG.
If the reaction strengths varied in each panel cell then that could be an indication that there are multiple antibodies present.
Your screen cells are 3+ at immediate spin and weak (W)+ at AHG. Your auto control is negative for both phases. Some of your antibody panel cells are 3+ at immediate spin and negative at AHG. What should you suspect?
A. A warm autoantibody is present
B. A cold antibody may be present
C. Bad specimen draw
A;
High triglycerides may be caused by disorders such as type 2 diabetes, hypothyroidism, Cushing's sydnrome, liver disease, uremia, dysglobulinemia, nephrotic syndrome, and alcoholism can cause hypertriglyceridemia.
A 46-year old known alcoholic with liver damage is brought in the ER unconscious. One would expect his lipid values to be affected in what way?
A. Increased
B. Decreased
C. Normal
D. Unaffected by the alcoholism
C;
Iron deficiency anemia, or IDA, is associated with an increased TIBC as there is less iron to bind to transferrin. Microcytic, hypochromic red cell morphology, a decreased serum iron level, a decreased serum ferritin level, and a decreased hemoglobin level are all characteristics associated with IDA.
All of the following are characteristic findings in patients with iron deficiency anemia EXCEPT:
A. microcytic, hypochromic red cell morphology
B. decreased serum iron level
C. decreased total iron-binding capacity (TIBC)
D. decreased ferritin
E. decreased hemoglobin
A;
Anti-A, anti-P, anti-Leb, and anti-M all react best at 4o C as they are predominantly IgM antibodies. Other antibody group choices above include IgG antibodies such as anti-K, anti-s, anti-S, and anti-Fya, anti-Lub, etc. which react best at 37o C.
Which of the following groups of antibodies generally reacts most strongly at 4o C:
A. Anti-A, Anti-P1 , Anti-Leb , Anti-M
B. Anti-B, Anti-K, Anti-Lua , Anti-Fya
C. Anti-H, Anti-S, Anti-Jkb , Anti-Leb
D. Anti-A, Anti-K, Anti-Lub , Anti-s
C;
The federal government has categorized critical biological agents into three groups: A, B, and C. Those agents in category A are highest-priority because they can be easily disseminated or transmitted person-to-person.
The federal government has categorized critical biological agents into three groups: A, B, and C. Those agents in category A are highest-priority because they:
A. Cause moderate morbidity and low mortality.
B. Could be engineered for mass dissemination at some future date.
C. Can be easily disseminated or transmitted person-to-person.
B;
Entamoeba gingivalis resembles Entamoeba histolytica both in size and in nuclear characteristics. Entamoeba gingivalis may contain numerous cytoplasmic inclusions such as red blood cells, white blood cells, and bacteria.
I reside in the mouth where I measure approximately 17 micro meters.
A. Entamoeba coli trophozoite
B. Entamoeba gingivalis trophozoite
C. Acanthamoeba species trophozoite
D. Trichomonas vaginalis trophozoite

A;
First, the RBC indices must be calculated. The MCV ((Hct/RBC) x 10) = 71 fL. Since the reference range for the MCV is 80-100 fL, this anemia would be classified as microcytic. The MCH ((Hgb/RBC) x 10) = 19.3 pg. Since the reference range for the MCH is 27-33 pg, this would be considered hypochromic. Finally, the MCHC ((Hgb/Hct) X 100) = 27%. Since the normal range for the MCHC is 33%-36%, this would indicate hypochromia which correlates with the MCH findings. The correct answer is therefore microcytic, hypochromic anemia.
A patient is admitted to the emergency room with lethargy and pallor. The CBC results are as follows:
RBC = 4.1 x 1012/L
Hemoglobin = 7.9 g/cL
Hematocrit = 29%
How would you classify this anemia?
A. microcytic, hypochromic
B. normocytic, normochromic
C. macrocytic, normochromic
D. microcytic, hyperchromic
A;
Plasma concentrations of creatinine are used to assess renal function. Creatinine clearance is based on the serum creatinine level and is used to measure glomerular filtration rate, or GFR.
An increased serum level of which of the following analytes is MOST commonly associated with decreased glomerular filtration?
A. Creatinine
B. Uric acid
C. Urea
D. Ammonia
E. Glucose
D;
The last choice in this question is false. Rocky mountain spotted fever is NOT geographically restricted to the Rocky mountain region. In fact, according to the CDC, this disease is widely distributed east of the Rocky Mountains and also occurs in limited areas on the Pacific Coast.
Which one of the following statements is false?
A. Rickettsial infections are usually best diagnosed by specific serology, rather than the Weil-Felix test
B. Ehrlichiosis is transmitted by the lonestar tick
C. Rickettsia rickettsii causes Rocky mountain spotted fever
D. Rocky mountain spotted fever is almost always geographically restricted to the Rocky mountain region
C;
This patient is most likely suffering from sickle cell anemia. This cell, which is sickle-shaped, is indicative of the presence of hemoglobin S. Polychromasia is also commonly observed in sickle cell anemia.
After experiencing crippling pain in her chest, Elizabeth's mother rushes her to the Emergency Room. After a complete blood count and differential are ordered, the hematology technologist views many peripheral cells similar in appearance to those found in the image below. Which condition is most likely present?
A. beta thalassemia
B. myocardial infarction
C. sickle cell anemia
D. hemoglobin c disease
C;
If a drug is given at intervals that are the same as its half-life, it will take about 5 half-lives to reach steady state.
If a drug is given at intervals that are the same as its half-life, approximately how long will it take the drug to reach steady state?
A. It will be at steady state from the first dose.
B. It will take about two half-lives to reach steady state.
C. It will take about 5 half-lives to reach steady state.
D. It will never reach a steady state.
D;
Bicarbonate and Chloride form an exchanger to help regulate and buffer the body's pH.
The buffering capacity of blood is maintained by a reversible exchange process between bicarbonate and:
A. Sodium
B. Potassium
C. Calcium
D. Chloride
A;
Howell-Jolly bodies are composed of DNA and appear as small round ball-like inclusions inside the red cells. Usually only one Howell-Jolly body will be present in each red cell.
Single erythrocyte inclusions which are large, round, smooth and purplish-blue staining are most likely:
A. Howell-Jolly bodies
B. Heinz bodies
C. Basophilic stippling
D. Cabot rings
B;
Western blot analysis is frequently utilized as the confirmatory method of HIV detection.
Which of the following assays is routinely used for confirmation of HIV infections:
A. Southern blot
B. Western blot
C. In-situ hybridization
D. Radioimmunoassay
B;
hs-CRP is a more sensitive version of the C-reactive protein (CRP) test, a test that has been used for many years to assess inflammation in settings such as lupus, transplantation, infection, etc.
Which of the following cardiovascular risk markers is a more sensitive version of a test that is used to assess inflammation?
A. Oxidized-LDL
B. hs-CRP
C. ApoB/ApoA1
D. LpPLA2
C;
Measuring the turnaround times of troponin tests from the emergency department would provide valuable information. This data represents circumstances in which patient safety may be compromised if results are delayed and treatment is not started as soon as possible.
A laboratory manager wants to evaluate the timeliness of patient services in order to prevent medical errors caused by delay in treatment. Measuring the turnaround time for which of these analytes would provide the most valuable information?
A. Routine glucose tests from patients on medical floors
B. Lipid panels from the outpatient clinic
C. Troponin tests from the emergency department
B;
The presence of hyaline, septate hyphae, and a young conidiophore with a foot cell and a swollen vesicle in a fungus culture are excellent clues indicative of Aspergillus. Aspergillus has the ability to infect primarily immunocompromised hosts, and causes pneumonia and/or disseminates to other organs. Clinical specimens should be inoculated onto primary isolation media, such as Sabouraud's dextrose agar. Aspergillus spp. are fast growing and can be white, yellow, yellow-brown, brown to black or green in color.
The presence of hyaline, septate hyphae, and a young conidiophore with a foot cell and a swollen vesicle in a fungus culture are excellent clues indicative of:
A. Acremonium
B. Aspergillus
C. Paecilomyces
D. Penicillium
E. Scopulariopsis
A;
Bacitracin susceptibility is a presumptive test for the identification of Lancefield group A Streptococcus.
Which of the following is a presumptive test for the identification of Lancefield group A Streptococcus:
A. Bacitracin susceptibility
B. Positive coagulase
C. Hippurate hydrolysis
D. Gram stain
D;
Valine substitutes for glutamic acid in the Beta 6 position to produce HbS.
To produce hemoglobin S, glutamic acid that is normally present in the sixth position on the beta globin chain is substituted with which of the following?
A. Cystine
B. Guanine
C. Thyamine
D. Valine